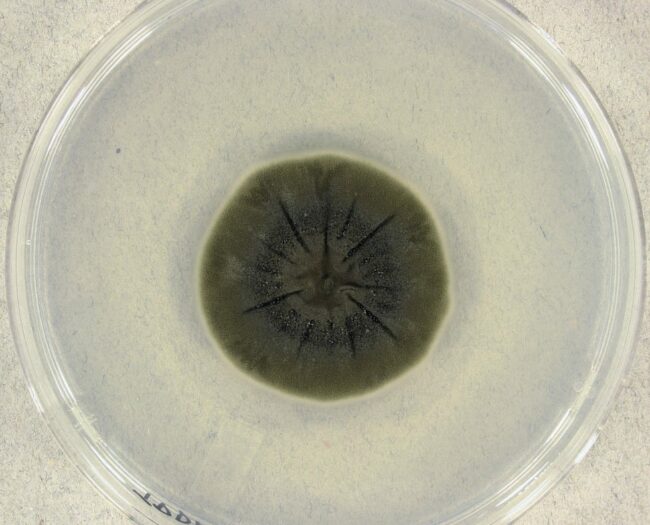
cladosporium-sphaerospermum-colony-693c715d33d90.jpg

Eternity Director Shares His Thoughts on the Film’s Ending
… into the sunset. However, the film's director, David Freyne … Eternity Director Delves into the Film's Classic Rom-Com … to most who enjoyed the film's concept, that tension … critics have already compared the movie to classic screwball comedies and …